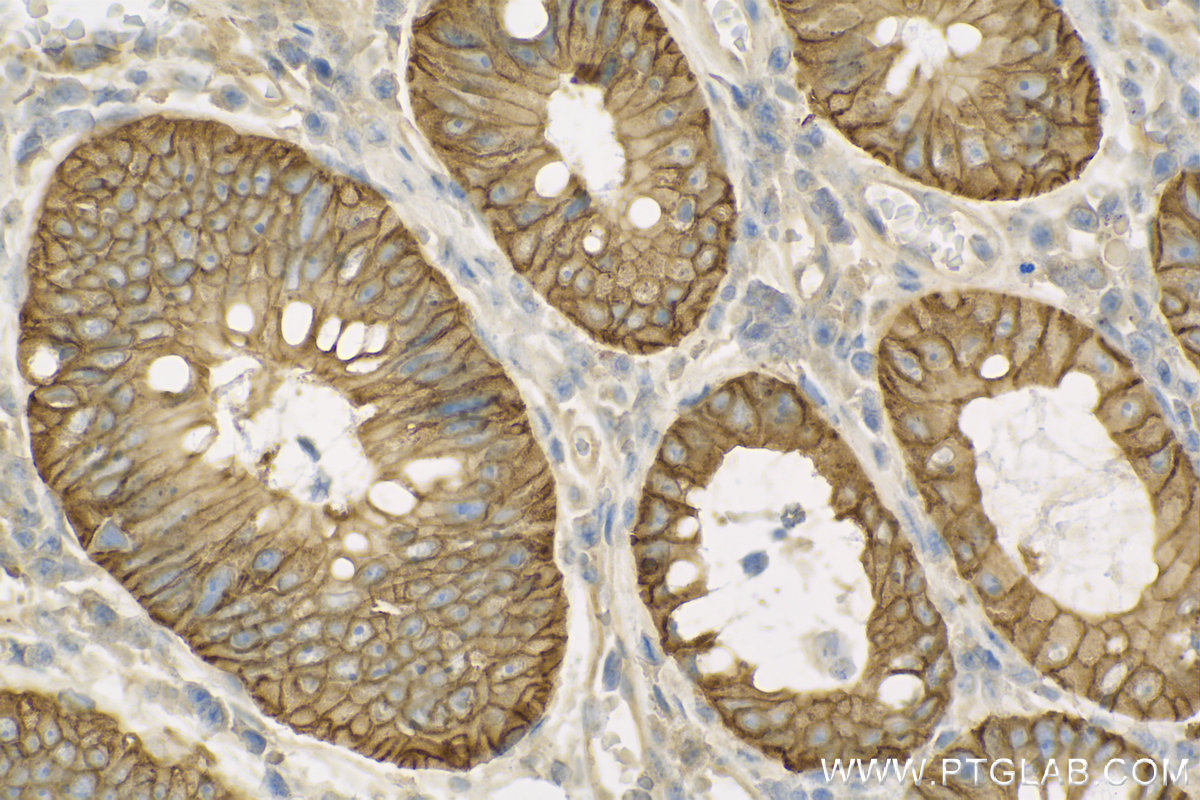

验证数据展示
经过测试的应用
| Positive WB detected in | mouse brain tissue, 37°C incubated mouse brain tissue |
| Positive IHC detected in | human colon cancer tissue Note: suggested antigen retrieval with TE buffer pH 9.0; (*) Alternatively, antigen retrieval may be performed with citrate buffer pH 6.0 |
| Positive IF/ICC detected in | A549 cells |
For optimal WB detection with 13884-1-AP, we do not recommend boiling the sample after lysis.
推荐稀释比
| 应用 | 推荐稀释比 |
|---|---|
| Western Blot (WB) | WB : 1:1000-1:4000 |
| Immunohistochemistry (IHC) | IHC : 1:50-1:500 |
| Immunofluorescence (IF)/ICC | IF/ICC : 1:200-1:800 |
| It is recommended that this reagent should be titrated in each testing system to obtain optimal results. | |
| Sample-dependent, Check data in validation data gallery. | |
产品信息
13884-1-AP targets NKCC1/SLC12A2 in WB, IHC, IF/ICC, IP, ELISA applications and shows reactivity with human, mouse, rat samples.
| 经测试应用 | WB, IHC, IF/ICC, ELISA Application Description |
| 文献引用应用 | WB, IHC, IF, IP |
| 经测试反应性 | human, mouse, rat |
| 文献引用反应性 | human, mouse, rat, pig |
| 免疫原 |
CatNo: Ag4991 Product name: Recombinant human SLC12A2 protein Source: e coli.-derived, PGEX-4T Tag: GST Domain: 759-1150 aa of BC033003 Sequence: GSSTQALTYLNALQHSIRLSGVEDHVKNFRPQCLVMTGAPNSRPALLHLVHDFTKNVGLMICGHVHMGPRRQAMKEMSIDQAKYQRWLIKNKMKAFYAPVHADDLREGAQYLMQAAGLGRMKPNTLVLGFKKDWLQADMRDVDMYINLFHDAFDIQYGVVVIRLKEGLDISHLQGQEELLSSQEKSPGTKDVVVSVEYSKKSDLDTSKPLSEKPITHKVEEEDGKTATQPLLKKESKGPIVPLNVADQKLLEASTQFQKKQGKNTIDVWWLFDDGGLTLLIPYLLTTKKKWKDCKIRVFIGGKINRIDHDRRAMATLLSKFRIDFSDIMVLGDINTKPKKENIIAFEEIIEPYRLHEDDKEQDIADKMKEDEPWRITDNELELYKTKFYEPC 种属同源性预测 |
| 宿主/亚型 | Rabbit / IgG |
| 抗体类别 | Polyclonal |
| 产品类型 | Antibody |
| 全称 | solute carrier family 12 (sodium/potassium/chloride transporters), member 2 |
| 别名 | NKCC1,SLC12A2, NKCC1, SLC12A2, Basolateral Na K Cl symporter, Basolateral Na-K-Cl symporter |
| 计算分子量 | 131 kDa |
| 观测分子量 | 150-160 kDa |
| GenBank蛋白编号 | BC033003 |
| 基因名称 | NKCC1/SLC12A2 |
| Gene ID (NCBI) | 6558 |
| RRID | AB_2188522 |
| 偶联类型 | Unconjugated |
| 形式 | Liquid |
| 纯化方式 | Antigen affinity purification |
| UNIPROT ID | P55011 |
| 储存缓冲液 | PBS with 0.02% sodium azide and 50% glycerol, pH 7.3. |
| 储存条件 | Store at -20°C. Stable for one year after shipment. Aliquoting is unnecessary for -20oC storage. |
背景介绍
The Na-K-Cl cotransporter sodium-potassium-chloride cotransporter 1 (NKCC1), encoded by the SLC12A2 gene, is an intensively studied member of the CCC family. NKCC1 is a membrane protein and plays fundamental roles in regulating trans-epithelial ion movement, cell volume, chloride homeostasis and neuronal excitability. NKCC1 assembles into a dimer, with the first ten transmembrane (TM) helices harboring the transport core and TM11-TM12 helices lining the dimer interface(PMID: 32081947). The observed molecular weight of NKCC1 is about 140 kDa, glycosylated NKCC1 is detected a band at ∼170 kDa (PMID: 22723696).
实验方案
| Product Specific Protocols | |
|---|---|
| IF protocol for NKCC1/SLC12A2 antibody 13884-1-AP | Download protocol |
| IHC protocol for NKCC1/SLC12A2 antibody 13884-1-AP | Download protocol |
| WB protocol for NKCC1/SLC12A2 antibody 13884-1-AP | Download protocol |
| Standard Protocols | |
|---|---|
| Click here to view our Standard Protocols |
发表文章
| Species | Application | Title |
|---|---|---|
PLoS Biol Early uneven ear input induces long-lasting differences in left-right motor function. | ||
Front Immunol Myeloid-derived growth factor promotes M2 macrophage polarization and attenuates Sjögren's syndrome via suppression of the CX3CL1/CX3CR1 axis | ||
PLoS Biol The NKCC1 ion transporter modulates microglial phenotype and inflammatory response to brain injury in a cell-autonomous manner. | ||
J Neurosci The severity of vestibular dysfunction in deafness as a determinant of comorbid hyperactivity or anxiety. | ||
Front Mol Neurosci Unilateral optogenetic kindling of hippocampus leads to more severe impairments of the inhibitory signaling in the contralateral hippocampus |